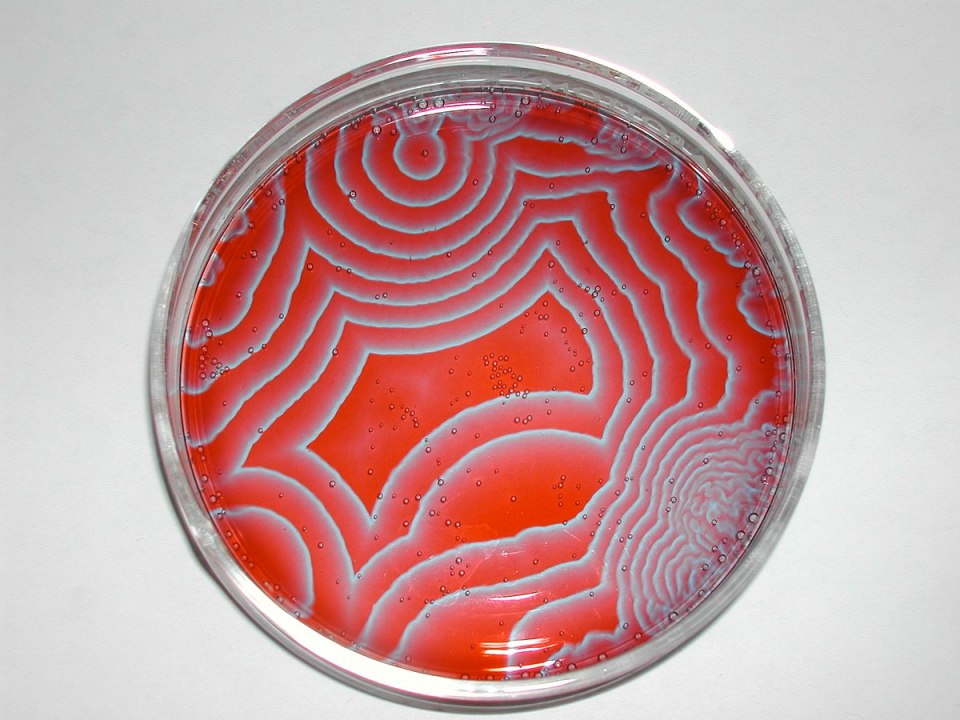
A famous oscillatory chemical reaction propagating across a petri dish.

Why do we need Systems Biology to help science slow or stop aging? That would be the most profound medical breakthrough since antibiotics. I think systems biology is the key and I spent the last month learning about how it relates to aging research, and I’ve tried to summarize my thoughts here and in a YouTube video (which you can check out at this link). So: what even is Systems biology?
Imagine we have a little miniature world, like a terrarium.
We can break that down: it has grass, sheep that eat the grass, and wolves that eat the sheep. We can study those parts: how much grass do sheep need to eat to survive? How many sheep do wolves need to eat?
Most of biology has been about breaking things down. To understand the creature, look at the organs. To understand the organs, look at the cells. To understand the cells, look at its individual biochemicals.
Systems Biology is concerned with zooming way back out and putting all of that together with computer simulations. The terrarium is an analogy for our body. And when everything is steady, that’s homeostasis and health. There is just enough grass for all the sheep, just enough sheep for the wolves to eat Everything is in balance. As the system drifts from a stable resilient state into disorder and fragility, we call that aging.
Our goal is to understand how systems (like this terrarium or our own bodies) STAY balanced and health. We need to look at the whole system, not just the way that sheep or grass or wolves behave on their own. If we can really understand how these systems behave we can keep them from falling apart.
I started with a perspective piece by Cohen et al. The conclusion is a hypothesis: aging is a change in an emergent property of a complex system and to understand aging, we need to understand it as a complex system. Then we can study how that system breaks down over time.
This is important: Age is the single cause that makes every other medical problem worse. Every person who gets injured, every person with an infection, every person with cancer
They all have a better chance of coming through OK if they are young (or if their biology behaves as if they were young and resilient).So, what does it mean to “understand a complex system?” In the terrarium model, it means being able to predict the kind of real behavior of the populations of the different creatures. The populations of creatures in our terrarium start off stable. There’s just enough grass so the sheep don’t starve, and just enough wolves to keep the sheep from growing further. It’s like the Circle of Life (like in that cartoon) but it’s math.

The Lotka Volterra mathematical model is a set of 2-equations that predicts the behavior of the different populations over time. Under some conditions, the equations predict a steady state with fairly constant populations (that’s like health). But even this toy system can produce swings between overpopulation and near-extinction, until it breaks down entirely. This Wilensky NetLogo program is an agent based model of the same system (so the kind of computer simulation is a little different from Lotka-Volterra but the idea is to use a computer to simulate the system).
It’s like a zero-player videogame where there are lots of little videogame sheep and wolves and tufts of grass. They videogame creatures behave according to rules that are carefully defined to perform the simulation. The green color is the amount of grass. There are little cartoon wolves and little cartoon sheep. Down in the lower left, you can see a graph of the different populations change over time.
When you run the simulation, there are waves of green as the grass gets overpopulated. Then the sheep population explodes and consumes all the grass and the green color fades. The wolf population booms after the sheep, and resets the whole thing in a cycle, over and over. At some point, we might think “the grass population is too low, let’s turn up grass growth rate. That will make everything better.”
But when we speed up again, what we see is a big spike of grass, then sheep, then wolves, then collapse, and the wolves go extinct. It’s not obvious why adding more grass makes the wolves go extinct, but a systems model helps us understand that. The population waves got too big, and then the system broke.
Population swings happen in the real world, too. In Canada, the lynx eat the rabbits. And over decades, we can see boom-and-bust cycles. When the rabbits multiply and are plentiful, the lynx eat all they want. Then the lynx get overpopulated and eat all the rabbits. But then the rabbit population is low and there’s not enough to eat. So the lynx population declines again. And so the rabbits multiply, starting the cycle over.
But that’s a ecosystem. What about chemistry?
Image Credit: Stephen Morris from Toronto, Canada, CC BY 2.0 https://creativecommons.org/licenses/by/2.0, via Wikimedia Commons
The Belousov-Zhabotinsky Reaction looks almost alive, but it’s just chemistry (but it’s very interesting chemistry). It’s a really interesting challenge for computational simulation. We know exactly what goes into this reaction, and yet its behavior is really hard to predict. Overall, it’s simple: cerium catalyzes bromate (A) and malonic acid (and its derivatives B) reacting to form some products we can abbreviate P. If you just look at this net reaction, you get no hints of the oscillating SYSTEM inside.
Along the way to products, it the reaction produces intermediates. Bromous acid, bromide ions and Ce4+ which Is bright yellow and produces most of the color change
Then those intermediates consume each other to make the products. If we stir the reaction, the waves occur in time. Researchers are still adding to this list as they examine the reaction more closely. One published model has 80-reactions and 26-different chemicals. But I got a pretty good understanding by studying the simpler system described by Irina Barzykina.
The oscillations of Ce4+ concentration happen because Ce4+ is produced exponentially with bromous acid. But then Ce4+ is reduced back to Ce3+. That makes Bromide, and bromide consumes all of the bromous acid, shutting down the production of Ce4+. The experimental result we can see (the brightly colored Ce4+ blowing up then settling down again) matches the simulation prediction, plus we get the simulation of bromous acid and Bromide (which are invisible to the eye).
This is more like systems chemistry than systems biology, but I think it serves to show how computation and experiment can go together to reveal the invisible and predict the possible.
Ultimately, this is the process is bromate and malonic acid (and its derivatives) reacting to form products. If you just look at this net reaction, you get no hints of the oscillating SYSTEM inside. Animal life is just the oxidation food in the presence of oxygen, but that doesn’t really capture the emergent properties that we are interested in. If we want to understand the SYSTEM we need a SYSTEM level model.
And biology is far more complex than the BZ reaction. Even just one part of energy metabolism, the Krebs cycle, is more complex. And the krebs cycle is one little part of the whole metabolome of e-coli. And that’s just one (relatively simple) cell. So if we want to integrate all of the complexity of human biolgy, we need computer simulation.
I read a more recent 2021 paper by Dato et al. that spells out next steps in applying this approach to aging. The paper suggests that we need to start with -omics data (like genomics, the measurement of the genome, all of the DNA in a cell, or proteomics, the measurement of all of the protein in the cell). We can that data and put the results into clever simulations. If we understand those results well enough, we can find good biomarkers for diseases and plan interventions like diet and targeted drugs.
I feel like I have a better idea of the Cohen paper now. We can start to model systems like the immune and inflammatory system. Out in the world, we encounter germs,
our body has an inflammatory response. If all goes well, the germs are eliminated and we return to a stable state of healthy homeostasis. If that system is a little like the grass-sheep-wolves system, then we have to understand the details before we intervene. Just turning something up or down could result in some really counterintuitive behavior (like how adding grass drove wolves extinct in my run of the simulation).
Are you interested in Aging Biology? Do you have questions you would like to see answered? Drop me a link in the comments, or send me an email or voicemail! There’s a temporary email address and phone number in the description and pinned comment. Get in touch! Maybe I can use your question/comment in a future video. I will leave you anonymous unless you request otherwise.
Contact info for Science Questions:
Temporary email: comments@peterallenlab.com
Voicemail number: +1 512 487 7544
References:
Cohen, Alan A. “Complex Systems Dynamics in Aging: New Evidence, Continuing Questions.” Biogerontology 17 (2016): 205–20. https://doi.org/10.1007/s10522-015-9584-x
Dato, Serena, Paolina Crocco, Nicola Rambaldi Migliore, and Francesco Lescai. “Omics in a Digital World: The Role of Bioinformatics in Providing New Insights Into Human Aging.” Frontiers in Genetics 12 (2021). https://doi.org/10.3389/fgene.2021.689824
Voit, Eberhard O. Systems Biology: A Very Short Introduction. Oxford University Press, 2020.
Mathematical Biology (Chasnov) By Jeffrey R. Chasnov, Hong Kong University of Science and Technology CC BY 4.0. Chapter 1.4. https://math.libretexts.org/Bookshelves/Applied_Mathematics/Mathematical_Biology_(Chasnov)
Wilensky, U. (1997). NetLogo Wolf Sheep Predation model. http://ccl.northwestern.edu/netlogo/models/WolfSheepPredation. Center for Connected Learning and Computer-Based Modeling, Northwestern University, Evanston, IL. Creative Commons Attribution-NonCommercial-ShareAlike 3.0 License.https://creativecommons.org/licenses/by-nc-sa/3.0/
E.P. Odum, Fundamentals of Ecology, 1953. via Chasnov.
Українська by Zlir’a [Metabolism_diagram.svg] by , CC0, via Wikimedia Commons. https://upload.wikimedia.org/wikipedia/commons/3/35/Metabolism_diagram.svg
Barzykina, Irina. “Chemistry and Mathematics of the Belousov–Zhabotinsky Reaction in a School Laboratory.” Journal of Chemical Education 97, no. 7 (July 14, 2020): 1895–1902. https://doi.org/10.1021/acs.jchemed.9b00906.
Осцилаторни реакции (хемиско нишало).ogg [English: Oscillatory reactions] by Дени Ингилизовски, CC BY-SA 4.0 https://creativecommons.org/licenses/by-sa/4.0, via Wikimedia Commons https://commons.wikimedia.org/wiki/Category:Belousov-Zhabotinsky_reaction
Citric Acid Cycle Graphic.jpeg by Marisakastner, CC BY-SA 4.0 https://creativecommons.org/licenses/by-sa/4.0, via Wikimedia Commons https://commons.wikimedia.org/wiki/File:Citric_Acid_Cycle_Graphic.jpeg
Evolution_of_Belousov-Zhabotinsky_reaction.gif by Wiktor, CC BY-SA 3.0 https://creativecommons.org/licenses/by-sa/3.0, via Wikimedia Commons
https://commons.wikimedia.org/wiki/File:Evolution_of_Belousov-Zhabotinsky_reaction.gif
Illustrations where not otherwise noted were created with Dall-E 3 and MidJourney, composited in Photoshop and and released under Creative Commons Attribution 4.0 (CC BY 4.0) International License (http:// creativecommons.org/licenses/by/4.0/), which permits unrestricted use, distribution, and reproduction in any medium, provided you give appropriate credit to the original author(s) and the source, provide a link to the Creative Commons license, and indicate if changes were made.
